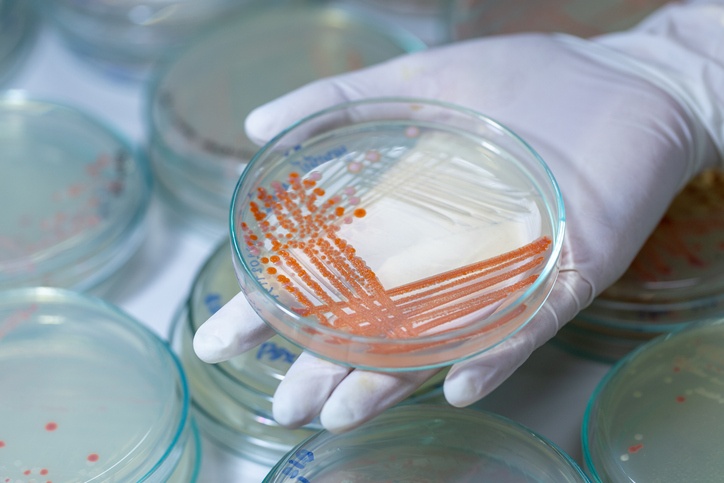

Content Spotlight
Podcast: MilliporeSigma says education vital to creating unbreakable chain for sustainability
MilliporeSigma discusses the importance of people, education, and the benefits of embracing discomfort to bolster sustainability efforts.
As it expands capacity in Switzerland, Lonza says demand for antibody fragments, scaffolds and bioconjugates services is driving microbial manufacturing.
Contract development and manufacturing organization (CDMO) will add a sixth microbial manufacturing facility at its biopark in Visp, Switzerland, currently under construction.
The 3,000 L scale microbial facility will be used to service an extended manufacturing agreement with Servier, producing the asparaginase-based active pharmaceutical ingredient (API) for its acute lymphoblastic leukemia (ALL) therapies.

Image: iStock/Sinhyu
Speaking with Lonza directors Clemens Jakobi and Axel Erler, the additional plant represents an increased demand for microbial biomanufacturing services that the CDMO is seeing across the industry.
“We have observed a very strong demand increase for manufacturing solutions for antibody fragments, scaffolds, nanobodies, but also bioconjugates over the last years,” said Jakobi, commercial director, Lonza Pharma & Biotech.
“And this trend continues, driving microbial fermentation fast forward as bacteria and yeasts can easily express smaller biomolecules. On top of this, drug substance development in microbial is usually faster, and microbial processes can be optimized for yield and scale.”
Jakobi added the recent push for vaccine development arising out of the COVID-19 crisis, has also brought attention to microbial manufacture. “The need for vaccine manufacturing capacity, irrespective of the underlying manufacturing technology, has increased. mRNA manufacturing requires pDNA as a key raw material, which also originates from microbial manufacturing. And we are proud that Lonza masters both technologies.”
Erler, associate director of Commercial Development, Microbial Biopharmaceuticals at Lonza, said that while microbial fermentation handles a much larger degree of molecular diversity, challenges remain.
“The necessity of molecule-tailored manufacturing processes requires an in-depth know-how and associated with that – capacity for development services. And of course, we are expanding our services in-sync with the expansion of our manufacturing capacities.”
He added that the team in Visp has been involved for over 30 years in microbial fermentation and continues to grow steadily. “Today, our end-to-end offering ranges from an extensive microbial expression toolbox over clinical supply up to profound experience in the market launch of new products and subsequent commercial production.”
Lonza currently offers small-scale (70 L and 1,000 L) and large-scale (15,000 L) microbial fermentation capacity, Jakobi said. “Given that the demand is quite strong, our ambition is to use as much of the capacity as possible to provide patients with access to life-saving therapies. That is why we are now expanding our capacities to extend our service offering in microbial.”
The new facility is expected to be operational in the second half of 2022 and Lonza expects to add 100 new staff to the existing microbial team.
You May Also Like